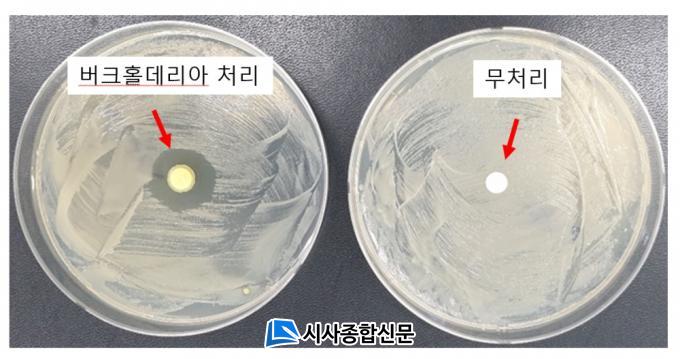

이는 본격적인 장마와 더위가 시작되면서 한번 감염되면 치료가 불가능한 고추 청고병 발생을 예방하는 취지에서 마련했다.
고추 청고병은 세균성병원균(Ralstonia solanacearum)이 원인균으로 뿌리로부터 병원균이 침입하여 식물 줄기의 내부 수관을 막아 푸른 색깔로 급속히 고추를 말라 죽게 하여 지금까지 뾰족한 방제법이 없는 것으로 알려져 있다.
이번 실증 시험에 활용되는 미생물인 버크홀데리아(Burkholderia territorii SCAT001) 균주는 순창군농업기술센터에서 지난 2019년부터 개발에 성공해 올해 특허로 등록된 순창군 자체 개발 미생물이다.
관내 고추 재배농가 중 이번 실험에 참여해 미생물을 사용하고자 하는 농업인은 7일부터 순창군농업기술센터 미생물연구실을 방문해 사용 방법에 대한 교육을 받은 후 사용할 수 있다.
한편, 순창군농업기술센터 진영무 소장은 “이번 실증시험을 통해 고추, 토마토 등에 피해를 주고 있는 청고병을 미생물을 통해 예방한다”면 “앞으로도 농가소득 증대를 위해 지속적으로 유용미생물을 발굴해 농업인에게 공급해 나갈 것”이라고 말했다.


 2026.02.04 (수) 14:39
2026.02.04 (수) 14:39